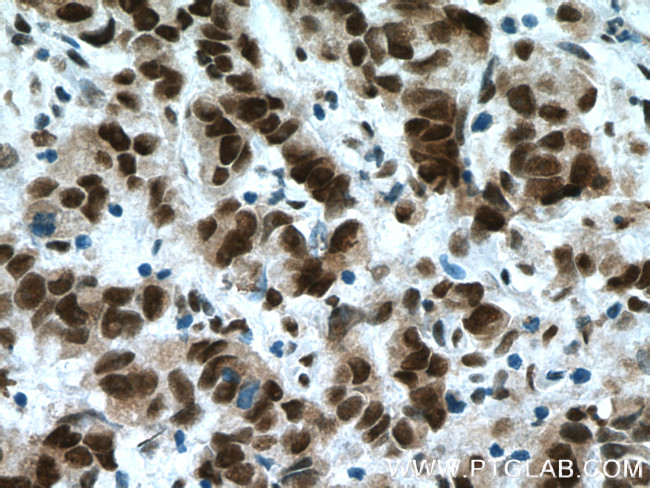
USP7 Antibody in Immunohistochemistry (Paraffin) (IHC (P))

Search
Proteintech
USP7 Polyclonal Antibody
{{$productOrderCtrl.translations['antibody.pdp.commerceCard.promotion.promotions']}}
{{$productOrderCtrl.translations['antibody.pdp.commerceCard.promotion.viewpromo']}}
{{$productOrderCtrl.translations['antibody.pdp.commerceCard.promotion.promocode']}}: {{promo.promoCode}} {{promo.promoTitle}} {{promo.promoDescription}}. {{$productOrderCtrl.translations['antibody.pdp.commerceCard.promotion.learnmore']}}
产品信息
26948-1-AP
种属反应
已发表种属
宿主/亚型
分类
类型
抗原
偶联物
形式
浓度
规格
纯化类型
保存液
内含物
保存条件
运输条件
产品详细信息
Immunogen sequence: MLLDNVENK MKGTCVEGTI PKLFRGKMVS YIQCKEVDYR SDRREDYYDI QLSIKGKKNI FESFVDYVAV EQLDGDNKYD AGEHGLQEAE KGVK
靶标信息
USP7 or HAUSP is a ubiquitin specific protease or a deubiquitylating enzyme that cleaves ubiquitin from its substrates. Since ubiquitylation (polyubiquitination) is most commonly associated with the stability and degradation of cellular proteins, HAUSP activity generally stabilizes its substrate proteins. HAUSP is most popularly known as a direct antagonist of Mdm2, the E3 ubiquitin ligase for the tumor suppressor protein, p53. Normally, p53 levels are kept low in part due to Mdm2-mediated ubiquitylation and degradation of p53. Interestingly, in response to oncogenic insults, HAUSP can deubiquitinate p53 and protect p53 from Mdm2-mediated degradation, indicating that it may possess a tumor suppressor function for the immediate stabilization of p53 in response to stress. Another important role of HAUSP function involves the oncogenic stabilization of p53. Oncogenes such as Myc and E1A are thought to activate p53 through a p19 alternative reading frame (p19ARF, also called ARF)-dependent pathway, although some evidence suggests ARF is not essential in this process. An intriguing possibility is that HAUSP provides an alternative pathway for safeguarding the cell against oncogenic insults.
仅用于科研。不用于诊断过程。未经明确授权不得转售。
生物信息学
蛋白别名: Chromosome 16p13.2 deletion syndrome; Deubiquitinating enzyme 7; Herpes virus-associated ubiquitin-specific protease; Herpesvirus-associated ubiquitin-specific protease; mHAUSP; Ubiquitin carboxyl-terminal hydrolase 7; ubiquitin specific peptidase 7 (herpes virus-associated); ubiquitin specific protease 7; ubiquitin specific protease 7 (herpes virus-associated); Ubiquitin thioesterase 7; ubiquitin thiolesterase 7; Ubiquitin-specific-processing protease 7; unnamed protein product; USP7; herpes virus-associated protease
基因别名: 2210010O09Rik; AA409944; AA617399; AU019296; AW548146; C16DELp13.2; C80752; DEL16P13.2; HAFOUS; HAUSP; TEF1; USP7
UniProt ID: (Human) Q93009, (Mouse) Q6A4J8
Entrez Gene ID: (Human) 7874, (Mouse) 252870